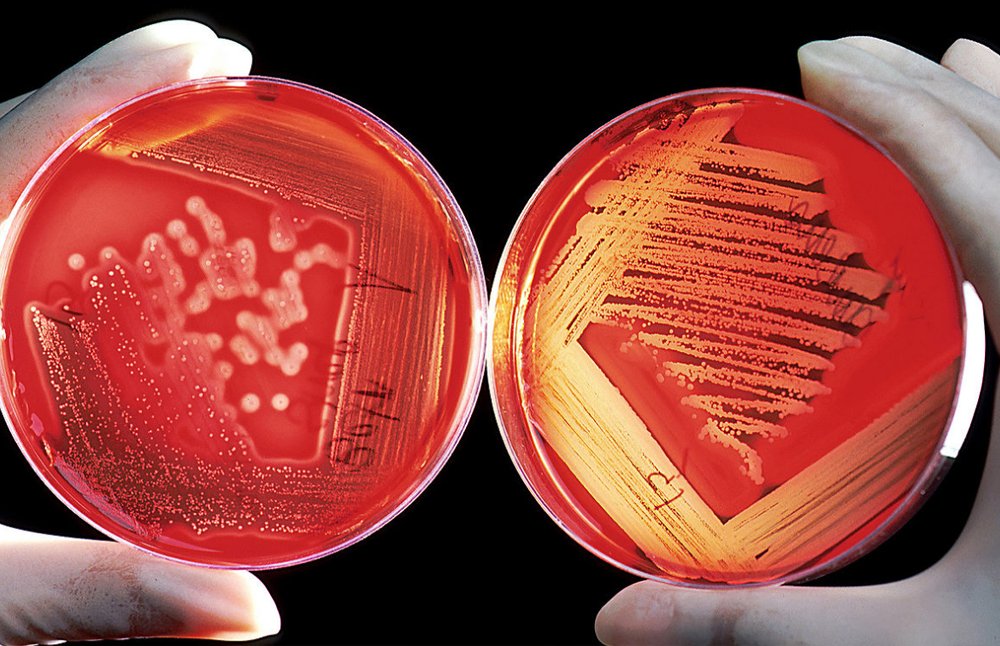

O que é um ágar? Por que o ágar é importante para a microbiologia?
Ágar é um elemento solidificador amplamente utilizado na preparação de meios de cultura, que devem estar isentos de quaisquer microrganismos contaminantes para facilitar a identificação, crescimento e desenvolvimento de outros microrganismos que crescem em substâncias artificiais de alimentos preparadas em laboratório, denominado cultura.
O ágar é um componente essencial para o desenvolvimento da microbiologia moderna e tem sido amplamente utilizado na criação e cultivo de bactérias, fungos e outros micro-organismos. O uso desse composto garante um ambiente estável para o crescimento das células, permitindo assim a identificação precisa dos micróbios presentes nos meios de cultura.
Qual a função do Ágar?
A microbiologia é uma área fascinante da ciência que estuda os microrganismos, tais como bactérias, fungos e vírus. Para entender esses seres minúsculos e seus processos biológicos, são necessárias ferramentas específicas para sua cultura em laboratório. É aí que entra o ágar.
O ágar é um polissacarídeo extraído de algas marinhas vermelhas e amplamente utilizado em microbiologia para produzir meios de cultura sólidos. Ele permite o crescimento dos microrganismos por conta própria ao fornecer nutrientes suficientes para isso.
Aplicações do Ágar
O ágar é amplamente utilizado em diversos setores, como a indústria alimentícia, farmacêutica e de cosméticos. Na área da microbiologia, o ágar é empregado na produção de meios de cultura para o crescimento e identificação de micro-organismos.
Além disso, os laboratórios utilizam o ágar em placas de Petri para cultivar bactérias e fungos. Essa técnica permite que os pesquisadores estudem as características das colônias, tais como tamanho, forma e coloração.
Qual a importância do Ágar em Meios de Cultura?
O ágar , também conhecido como agar-agar, é um polissacarídeo complexo extraído de algas marinhas vermelhas e tem se mostrado essencial nos Meios de Cultura. A sua capacidade para solidificar meios líquidos em temperatura ambiente torna-o um ingrediente chave na preparação de meios sólidos que são utilizados no cultivo e identificação de microrganismos.
Em laboratórios microbiológicos, o ágar é utilizado para cultivar uma ampla gama de bactérias, fungos e leveduras. Ele fornece aos microrganismos nutrientes necessários para seu crescimento e desenvolvimento. Além disso, a textura gelatinosa do meio permite que as colônias cresçam sem interferência mútua
Como preparar o Ágar para uso em Meios de Cultura?
Para preparar o ágar para uso em Meios de Cultura, é necessário seguir algumas etapas simples. Primeiramente, deve-se pesar a quantidade necessária de Ágar e adicionar em um recipiente com água destilada. A proporção recomendada é geralmente de 1,5% a 2%, variando conforme as necessidades específicas do meio.
Em seguida, é preciso aquecer o recipiente até que todo o ágar esteja dissolvido na água destilada. Para isso, pode ser utilizado um banho-maria ou uma placa aquecedora. É importante mexer bem durante todo o processo para evitar grumos e garantir uma dissolução homogênea.
Após a completa dissolução do ágar na água destilada, é hora de esterilizar o meio por autoclavagem ou filtração em membrana estéril. Essa etapa garante que não haja contaminações no meio e que ele esteja pronto para uso.
Ágares Importantes
Ágar Bacteriológico
O ágar bacteriológico é comumente usado como meio de cultura para microorganismos. É útil para o processo de fermentação. O ágar-ágar serve como conservante no processamento de alimentos. Ele também possui várias outras aplicações, como um emulsificante, carreador, lubrificante, estabilizador, desintegrante laxante nas indústrias farmacêutica e cosmética.
Ágar Batata
O Potato Dextrose Agar é um meio de uso geral para leveduras e bolores que pode ser suplementado com ácido ou antibióticos para nibir o crescimento de bactérias. O ágar dextrose batata é um meio de crescimento basal microbiológico comum feito de infusão de batata e dextrose usada para o crescimento de fungos.
O ágar batata é recomendado pela APHA e FDA para contagem de placas de leveduras e bolores no exame de alimentos e laticínios. É um meio de uso geral para leveduras e bolores que podem ser suplementados com ácido ou antibióticos como cloranfenicol, ácido tartárico e clortetraciclina podem ser adicionados como agentes seletivos e para inibir o crescimento bacteriano. O PDA pode ser usado para o cultivo de leveduras e bolores clinicamente significativos. O PDA também é útil para manter culturas de estoque de certos dermatófitos.
Ágar Bhi
Ágar de infusão de cérebro e coração ,um meio sólido para o cultivo de bactérias patogênicas exigentes, como Streptococci e Neisseria . O ágar BHI é um meio sólido recomendado para o cultivo de bactérias patogênicas, leveduras e fungos amostras clínicas e não clínicas.
Organismos fastidiosos com requisitos nutricionais exigentes podem ser cultivados em meios de infusão.As infusões de carne foram incluídas nos primeiros meios usados para o cultivo de bactérias .
.
Ágar Emb
Ágar Eosina Azul de Metileno, meio sólido versátil para a diferenciação de à Escherichia coli e Aerobacter aerogenes , para identifcation de Candida albicans e para a identificação de coagulase-positiva Staphylococcus .
O ágar Eosin Methylene Blue (EMB) é um meio microbiológico diferencial, que inibe ligeiramente o crescimento de bactérias Gram-positivas e fornece um indicador de cor que distingue entre organismos que fermentam lactose (por exemplo, E. coli ) e aqueles que não fermentam (por exemplo, Salmonella , Shigella ).
Os problemas causados pela preparação defeituosa do meio de cultura incluem:
- Taxas de crescimento/recuperação reduzidas
- Morfologia colonial atípica
- Inibição do organismo alvo
- Falha em inibir a flora concorrente
- Vida útil reduzida do meio preparado
Prazo de validade do Ágar
O ágar é um componente fundamental para os meios de cultura utilizados em laboratórios, permitindo o crescimento e a reprodução de microrganismos. Porém, é importante ter em mente que esse produto tem uma data de validade limitada.
O prazo de validade do ágar pode variar dependendo da marca e das condições de armazenamento. Geralmente, os fabricantes indicam uma validade média entre 2 a 3 anos. É importante verificar essa informação na embalagem antes de utilizar o produto.
Conclusão
Portanto, podemos concluir que o ágar é um componente essencial na produção de meios de cultura para a microbiologia. Sua capacidade de solidificar em temperatura ambiente e sua transparência são características únicas que permitem a visualização clara das colônias bacterianas.
Além disso, existem diferentes tipos de ágar que podem ser utilizados dependendo do tipo de micro-organismo ou finalidade do experimento. É importante seguir as instruções adequadas para preparar corretamente o meio e garantir resultados precisos.
Conheça nossa linha completa de Meios de Cultura.
Participe do nosso blog, envie seu comentário, dúvida ou sugestão.
AVISO DE DIREITOS AUTORAIS: Todo o material deste blog, sendo proibida toda e qualquer forma de plágio, cópia, reprodução ou qualquer outra forma de uso.
Qualquer dúvida técnica sobre os equipamentos contidos no portfólio SPLABOR, entre em contato com o Departamento de Vendas (sp@splabor.com.br)

A Splabor é uma empresa líder no ramo de fabricação de equipamentos para laboratório, especializada em oferecer uma ampla variedade de equipamentos para laboratórios, materiais e produtos para laboratório de alta qualidade.